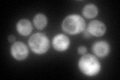
YBL039C
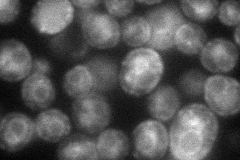
YBL039C
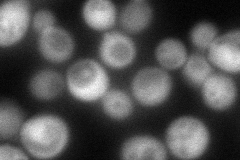
YBL039C
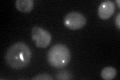
YBL039C

View description
Major CTP synthase isozyme (see also URA8), catalyzes the ATP-dependent transfer of the amide nitrogen from glutamine to UTP, forming CTP, the final step in de novo biosynthesis of pyrimidines; involved in phospholipid biosynthesis
Localization:
Intensity:
Fold change:
Significance:
-
C’ GFP library in SD
cytosol178.05 -
N' NOP1pr-GFP in SD
ER,vacuole63.3414 -
N' TEF2pr-mCherry in SD

missing0 -
N' NATIVEpr-GFP in SD
cytosol108.413 -
N' TEF2pr-VC and Cyto-VN in SD

#N/A0 -
C’ GFP library in SD+DTT

cytosol143.230.8No -
C’ GFP library in SD+H2O2

cytosol233.111.3No -
C’ GFP library in Starvation Media

cytosol53.80.3Yes -
C’ GFP library on the background of Pup2-DaMP
punctate -
C’ GFP library on the background of CCT mutant

cytosol217.8091.22327No
